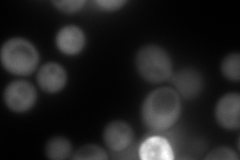

View description
N-succinyl-5-aminoimidazole-4-carboxamide ribotide (SAICAR) synthetase, required for 'de novo' purine nucleotide biosynthesis; red pigment accumulates in mutant cells deprived of adenine
Localization:
Intensity:
Fold change:
Significance:
-
C’ GFP library in SD

cytosol118.59 -
N' NOP1pr-GFP in SD

cytosol192.384 -
N' TEF2pr-mCherry in SD
cytosol289.554 -
N' NATIVEpr-GFP in SD

cytosol363.907 -
N' TEF2pr-VC and Cyto-VN in SD

#N/A0 -
C’ GFP library in SD+DTT

cytosol108.50.91No -
C’ GFP library in SD+H2O2

cytosol146.21.23No -
C’ GFP library in Starvation Media

nucleusN/AN/AYes -
C’ GFP library on the background of Pup2-DaMP

cytosol -
C’ GFP library on the background of CCT mutant

cytosol124.4931.04973No
